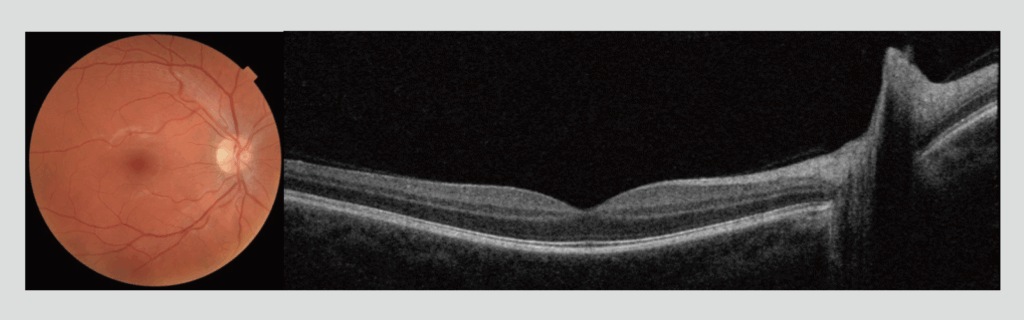
Figure 1: Maestro2 color fundus photograph and wide-field OCT images captured in a single scan

Efficiency in OCT Imaging: The Benefits of a Multi-Modality, Automated OCT
Efficiency is a primary practice management concern for today’s ophthalmology clinics because wasted time impacts patient satisfaction, frustrates doctors and staff, and leads to decreased revenues and profitability. Workflow is a key contributor to practice efficiency, making it critical to move patients through each part of the office visit as quickly as possible without sacrificing quality of care. Diagnostic testing is one part of the visit that can easily become a bottleneck and shorten the amount of time a patient gets to spend with the doctor. Optimizing the diagnostic data capture and review workflow as much as possible by minimizing the time at each instrument can significantly impact efficiency while ensuring patients receive the best possible care.
A comprehensive ophthalmic examination includes visual field assessment, fundus photography and optical imaging of the posterior pole and optic disc. Currently, color fundus photography for baseline documentation of disease and imaging using optical coherence tomography (OCT) are standard of care procedures for detecting and monitoring disease. Decreasing the time taken to obtain fundus photographs and OCT images would help to minimize diagnostic data capture time and would benefit patients, clinicians, and practices. Dr. David Friedman, MD, PhD, the Director of the Glaucoma service at Massachusetts Eye and Ear, believes that automation may be the future of efficient retinal imaging. “The Maestro2 captures retinal photos and OCT rapidly and with very little input from a technician. The image quality is excellent, and this device is well designed for rapid image acquisition with minimal training needed for the operator.”
Several different OCT instruments are FDA approved and available for clinical use in the US. One OCT instrument that has been gaining popularity in comprehensive eye care settings is the Maestro2 (Topcon Healthcare, Tokyo, Japan). The Maestro2 captures a color fundus photograph and wide-field 12mm x 9mm OCT in a single scan to provide a comprehensive view and analysis of the macula, parapapillary and optic disc regions (Figure 1). Multi-modal examination. Examination of the macula and optic disc are essential for effective detection and management of glaucoma (Figure 3)*1,2,3 as well as for screening or managing of macular disease (Figure 4). A recent study conducted at the New England College of Optometry assessed the total chair time required to capture images of the macula and optic disc in 50 healthy eyes and 20 diseased eyes using the Maestro2.



| Patient Cohort | Average Total Chair Time (min.) | Chair Time Range (min.) |
| All (n=70) | 2:06 | 1:03 – 4:31 |
| Healthy (n=50) | 2:03 | 1:03 – 4:23 |
| Diseased (n=20) | 2:16 | 1:13 – 4:31 |
Results
The average chair time to capture a Maestro2 3D Wide Scan (OCT + color fundus photograph) was two minutes six seconds. This rapid acquisition of multiple imaging modalities eliminates the need to move patients to a separate device for retinal photos, which saves a significant amount of time. In high volume clinics, this can translate to hours of time saved, which increases the number of patients that can be seen while still ensuring that a comprehensive evaluation of each eye is preserved. In addition, the Maestro2’s robotic automation for data capture not only decreases acquisition time but significantly reduces the level of technician expertise needed to acquire reliable images. The combination of these time saving functionalities of the Maestro2 provides a unique opportunity to improve patient care while enhancing the efficiency of any ophthalmology practice to increase financial returns.
Tim Bossie, OD, FAAO, Director of Owned Clinics, & Outreach Services at the New England College of Optometry noted that, “The Maestro 2 was significantly faster and easier than other imaging systems we’ve used in terms of acquisition, while delivering high quality fundus and OCT images. The combination of clinical efficiency and the multi-modality nature of the data produced make it a great device for any clinic setting.”
Study Method
All study participants were imaged using the Maestro 3D Wide scan (12mm X 9mm). Imagers recorded the time elapsed between study participants sitting down pre-imaging and standing up post-imaging as the total chair time. All scans were evaluated for poor quality, artifacts, and movement during capture, prior to exiting the capture mode and completion of acquisition.
1. Wollstein G, Schuman JS, Price LL, et al. Optical coherence tomography (OCT) macular and peripapillary retinal nerve fiber layer measurements and automated visual fields. Am J Ophthalmol. 2004;138(2):218-225.
2. Jeoung JW, Choi YJ, Park KH, et al. Macular ganglion cell imaging study: glaucoma diagnostic accuracy of spectral-domain optical coherence tomography. Invest Ophthalmol Vis Sci 2013;54:4422–9
3. Raza AS, Cho J, de Moraes CG, et al. Retinal ganglion cell layer thickness and local visual field sensitivity in glaucoma. Arch Ophthalmol. 2011;129(12):1529-1536
On-Demand Maestro2 Demo
Register now for instant access
Use the form below to register for instant access to an on-demand Maestro2 demo.



